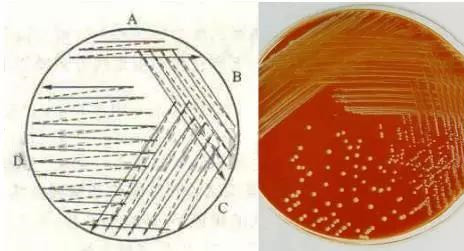

根據待檢樣品的性質、培養目的和所用培養基的種類,采用不同的接種方法。
1、平板劃線分離培養法
對混有多種細菌的樣品,采用劃線分離和培養,使原來混雜在一起的細菌沿劃線在瓊脂平板表面分離,得到分散的單個菌落,以獲得純種。劃線的形式有多種,可將一個平板分成四個不同面積的小區進行劃線,第一區(A區)面積最小,作為待分離菌的菌源區,第二和第三區(B、C區)是逐級稀釋的過渡區,第四區(D區)則是關鍵區,使該區出現大量的單菌落以供挑選純種用。為了得到較多的典型單菌落,平板上四區面積的分配應是D>C>B>A。
2、瓊脂斜面接種法
主要用于菌落的移種,以獲得純種進行鑒定和保存菌種等。用接種環(針)挑取單個菌落或培養物,從培養基斜面底部向上劃一條直線,然后再從底部沿直線向上曲折連續劃線,直至斜面近頂端處止。
3、穿刺接種法
此法多用于半固體培養基或三糖鐵、明膠等具有高層的培養基接種,半固體培養基的穿刺接種可用于觀察細菌的動力。接種時用接種針挑取菌落,由培養基中央垂直刺至距管底0.4cm處,再沿穿刺線退出接種針。三糖鐵等有高層及斜面之分的培養基,穿刺搞層部分,退出接種針后直接劃線接種斜面部分。

4、液體培養基接種法
用于各種液體培養基如肉湯、蛋白胨水、糖發酵管等的接種。用接種環挑取單個菌落,傾斜液體培養管,在液面與管壁交界處研磨接種物,使細菌均勻得散落在液體培養基中。此接種法應避免接種環與液體過多接觸。
5、傾注平板法
本法主要用于飲水、飲料、牛乳和尿液等樣品中的細菌計數。取純培養物的稀釋液或原樣品lml至無菌培養皿內,再將已融化并冷卻至45-50℃左右的瓊脂培養基15-20ml傾注入該無菌培養皿內,混勻,待凝固后置37℃培養,長出菌落后進行菌落計數,以求出每毫升樣品中所含菌數。
6、涂布接種法
涂布法接種是一種常用的接種方法,不僅可以用于計算活菌數,還可以利用其在平板表面生長形成菌苔的特點用于檢測化學因素對微生物的抑殺效應。將一定量的菌液或稀釋液加到瓊脂培養基表面,然后用滅菌的L型玻璃棒或棉拭子于不同的角度反復涂布,使被接種液均勻分布于瓊脂表面,然后貼上藥敏紙片,或直接培養,本法經培養后細菌形成菌苔。
二、高壓滅菌鍋滅菌效果的監測方法
高壓鍋的滅菌效果關系到最終試驗結果的成敗,因此,實驗室要定期對高壓鍋的滅菌效果進行監測,目前監測的方法主要有以下3種:
1、化學指示卡
化學指示卡只能監測滅菌鍋的滅菌溫度,并不能準確監測滅菌時間,通過顏色變化來達到監測效果。
優點是使用方便快捷,缺點是不能準確監測滅菌時間。
如果高壓鍋使用的頻率較高,建議每次都在需要滅菌的的材料外側使用化學指示卡作為標識。
2、留點溫度計
留點溫度計標化合格后方可用于驗證試驗。檢測前,需將溫度計的水銀柱甩至40℃以下。每次監測后留點溫度計的溫差應在1℃之間,則說明滅菌器內的溫度分布是均勻的。
如果高壓鍋使用的頻率較高,建議每個月用留點溫度計對高壓鍋滅菌效果進行監測。
3、生物指示劑
生物指示劑是一類特殊的活微生物制品,可用于確認滅菌設備的性能,滅菌程序的驗證,生產過程滅菌效果的監控等。
1)按結構分可分為片狀生物指示劑和自含式生物指示劑。一般來說都是用的自含式的多,就是里面有菌片,外面是密封的安瓿。
2)按培養時間可分為通用型生物指示劑和快速型生物指示劑。通用型生物指示劑根據芽孢復蘇后指示菌種新陳代謝引起培養液pH改變,通過酸堿指示劑變色來進行判讀,時間一般在24或48小時以上;而快速型生物指示劑根據芽孢復蘇后的酶促反應,通過熒光進行判讀,時間一般為3-4小時,同時國外正在研發更加快速的生物指示劑,有望在1小時之內得出結果。
生物指示劑也是GB15981-1995《消毒與滅菌效果的評價方法與標準》中推薦使用的壓力蒸汽滅菌效果的監測方法。
優點是能夠準確監測滅菌溫度和時間,缺點是所需時間較長。
建議每個季度用生物指示劑進行高壓鍋滅菌效果的監測。
三、定量檢測方法(平板法)注意事項
食品微生物學檢驗可分為定量檢驗和定性檢驗兩類,其中定量檢驗又以平板法和MPN法兩種最為常見。下面以平板法為例,簡單介紹下定量檢測中一些常見注意事項,以供大家在日常工作中參考。
1、均質效果對試驗結果的影響。均質過程是將樣品與稀釋液混勻的過程,如果均質效果不好就會使樣品中的微生物不能充分混勻到稀釋液中,那么試驗結果就不能體現樣品的真實情況。一般試驗數值都小于真實值,目前國標推薦的均質方式是旋轉刀均質器的均質杯法和拍擊式均質器的均質袋法。大家可以根據自己樣品的實際情況進行選擇。
2、十倍梯度稀釋對試驗結果的影響。十倍梯度稀釋對定量檢測方法的影響是很大的,因為它可以將試驗誤差成倍的放大。比如10-1到10-2稀釋時,如果只取了0.98mL,那么到10-5時,誤差就被放大了1000倍。所以在這步操作時一定注意取液量要準確,并且每次稀釋后,要將稀釋液混合均勻,再進行下一步稀釋。
3、平板接種的注意事項。無論是涂布還是傾注接種,都要讓微生物分布均勻,且盡量靠近中間,遠離邊緣,因為菌落生長在邊緣時,不容易讀取,且易連成片,在涂布時,要在平板中間加入稀釋液開始涂布,盡量不要將液體涂布到邊緣。在傾注時,也要將稀釋液加到平板中間,然后傾注培養基,并輕輕旋轉平板,使之混合均勻。
四、大腸菌群MPN法的常見問題
①試驗所依據的標準
首先,查看要求MPN值的單位,是MPN/g還是MPN/100g。如果是MPN/g,按照GB4789.3-2016進行試驗;如果是MPN/100g,依據衛生部頒布的通知要求,可以按照GB4789.3―2003進行試驗。
②雙料的接種和MPN表的檢索方法
如果制備的稀釋度為10-1、10-2、10-3。其中,10-1取10mL接種于3管雙料初發酵培養基中,另取10-11mL接種于3管單料初發酵培養基中,10-2取1 mL接種于3管單料初發酵培養基中。完成MPN法的初發酵接種。
最后判定結果時,要依據復發酵的結果來推出初發酵為陽性的管數,再結合初發酵接種的稀釋度為1,0.1,0.01。檢索MPN表進行判定,注意表內MPN值隨稀釋度的變化有相應的變化。
③如何判定產氣
在MPN法中,初發酵和復發酵陽性管的主要判定依據是產氣,但做樣品檢測時,很多時候大腸菌群的產氣量不多,在小導管中很難看到,這時不能直接判定為陰性。輕輕晃動試管,然后將試管傾斜一定角度,如果有大量小氣泡從底部升上來,并有逐漸增多的趨勢,可判定為陽性。
五、生化試驗可疑菌純化的目的
致病菌檢測過程中,生化試驗或者初步篩選以后確證性試驗以前,一般要求將可疑菌菌落純化于特定營養型平板上,比如單增李斯特檢驗使用TSA-YE進行可疑菌純化,沙門氏菌和志賀氏菌檢測使用營養瓊脂進行純化。可疑菌純化的目的有如下幾點:
1、根據純化以后的平板上生長的菌落大小及形態,可以判斷挑取的可疑菌是不是單獨的純菌落,有沒有發生菌落疊加現象。
2、生化試驗一般項目較多,選擇性分離平板上的可疑菌一般都帶有顏色,無法制作菌懸液。生長較小的可疑單菌落無法滿足接菌量要求,而且不能保證每個項目接菌量相同。實驗結果會有差異。而純化以后的平板上的所有菌落均來源于同一個單菌落,有大量的菌供生化試驗使用。
3、選擇性分離平板一般都成分復雜,并且有一定抑制性,其中可能含有某些對個別生化產生影響的物質。而用于純化的平板都是營養型的,不會對生化項目造成影響。
六、沙門氏菌檢驗中血清學試驗常見問題
血清學鑒定是沙門氏菌檢驗中的重要鑒定方法,包括菌體抗原(0)鑒定、鞭毛抗原(H)鑒定和Vi抗原鑒定。由于血清學試驗涉及的內容很多,所以我們在此給大家列出幾個常見問題,以供大家在日常工作中參考。
1、沙門氏菌判定時以生化試驗結果為主還是血清學試驗結果為主?
我們在判定時應該以生化試驗結果為主,在生化試驗的基礎上進行血清學判定。有的試驗人員會直接用多價血清進行試驗,不進行生化試驗,這是絕對不可取的。因為血清學的原理是抗原抗體結合,非沙門氏菌的微生物也有可能帶有沙門的類似抗原的。所以我們做鑒定的時候,必須先進行生化試驗,在生化試驗的基礎上進行血清學鑒定。
2、血清學試驗要做到什么程度?
如果我們只需要鑒定某個菌株是否屬于沙門氏菌,那只需要做0多價和H多價血清就可以了。如果需要鑒定某個菌株具體是什么沙門氏菌,比如是否為鼠傷寒沙門氏菌或是否為腸炎沙門氏菌,那就需要進行血清學分型試驗,從多價血清一直做到0抗原和H抗原的單因子,然后參照GB4789.4-2016沙門氏菌檢驗標準中附錄B的表格查找對應的沙門菌名。
3、0多價血清不凝集,就一定是0抗原陰性么?
我們在做0多價血清時,如果沒有凝集并不能直接判定為陰性,因為我們還要考慮Vi抗原的影響。Vi抗原屬于K抗原群,是會阻隔0抗原和相應抗體的結合,所以有Vi抗原存在時,0多價血清是不會凝集的。GB4789.4-2016沙門氏菌檢驗標準中提到已知具有Vi抗原的菌型有:傷寒沙門氏菌、丙型副傷寒沙門氏菌和都柏林沙門氏菌。因此,我們必須去除Vi抗原的影響。具體方法是將待檢菌做成濃菌液,放入100℃沸水中煮沸15-60分鐘,目的是破壞Vi抗原,然后再挑取菌液做0多價血清。如果還是不凝集,才能判定為陰性。
七、熒光實驗結果觀察
日常試驗中,經常會遇到大腸桿菌需要觀察熒光是情況。國標GB 4789.38-2012大腸埃希氏菌計數中第二法(VRBA-MUG計數),GB/T 5750.12-2006 水及水源水中的大腸埃希氏檢驗,都需要觀察熒光,可見熒光結果觀察的重要性。
MUG是4-甲基傘形酮-β-D-半乳糖苷的縮寫,該物質為β-半乳糖苷酶作用的底物,β-半乳糖苷酶與MUG結合并剪切β-半乳糖苷鍵,釋放熒光顯色基團4-甲基傘形酮,在紫外光(入=366nm)下觀察,培養物發出藍色熒光。
觀察熒光的條件:
1)紫外光為366nm波長;
2)在黑暗的環境下觀察,有助于更好的觀察熒光;
3)紫外燈燈管最好直接照射在待測平板或試管上,無玻璃等物品吸收紫外光。
4)使用空白管、陽性菌、陰性菌做對照。
推薦使用“簡易便攜式熒光檢測燈”,不但具備以上三個要求,而且避免了紫外燈直接照射人的情況,對實驗人員有所保護。
空白產熒光原因分析:
1)試管或平血洗涮不干凈所致。試管或平血中殘留4-甲基傘形酮,會導致空白有熒光。
2)觀察熒光的紫外燈不合適。紫外燈波長雖為366nm,但外側有玻璃燈罩、或者功率太大(瓦數太高、燈過亮)均會影響熒光效果。
3)試管或平血本身原因。有些試管或平血,本身由于質量原因,在紫外燈下自身就帶有光亮。使用前,可以先拿幾種試管或平血裝入蒸餾水,先在紫外燈下觀察一下,然后挑取亮度比較暗的容器使用。
建議:
建議做熒光試驗時,采用陽性對照菌同時觀察,可更簡單明了。








當前所在頁面:















